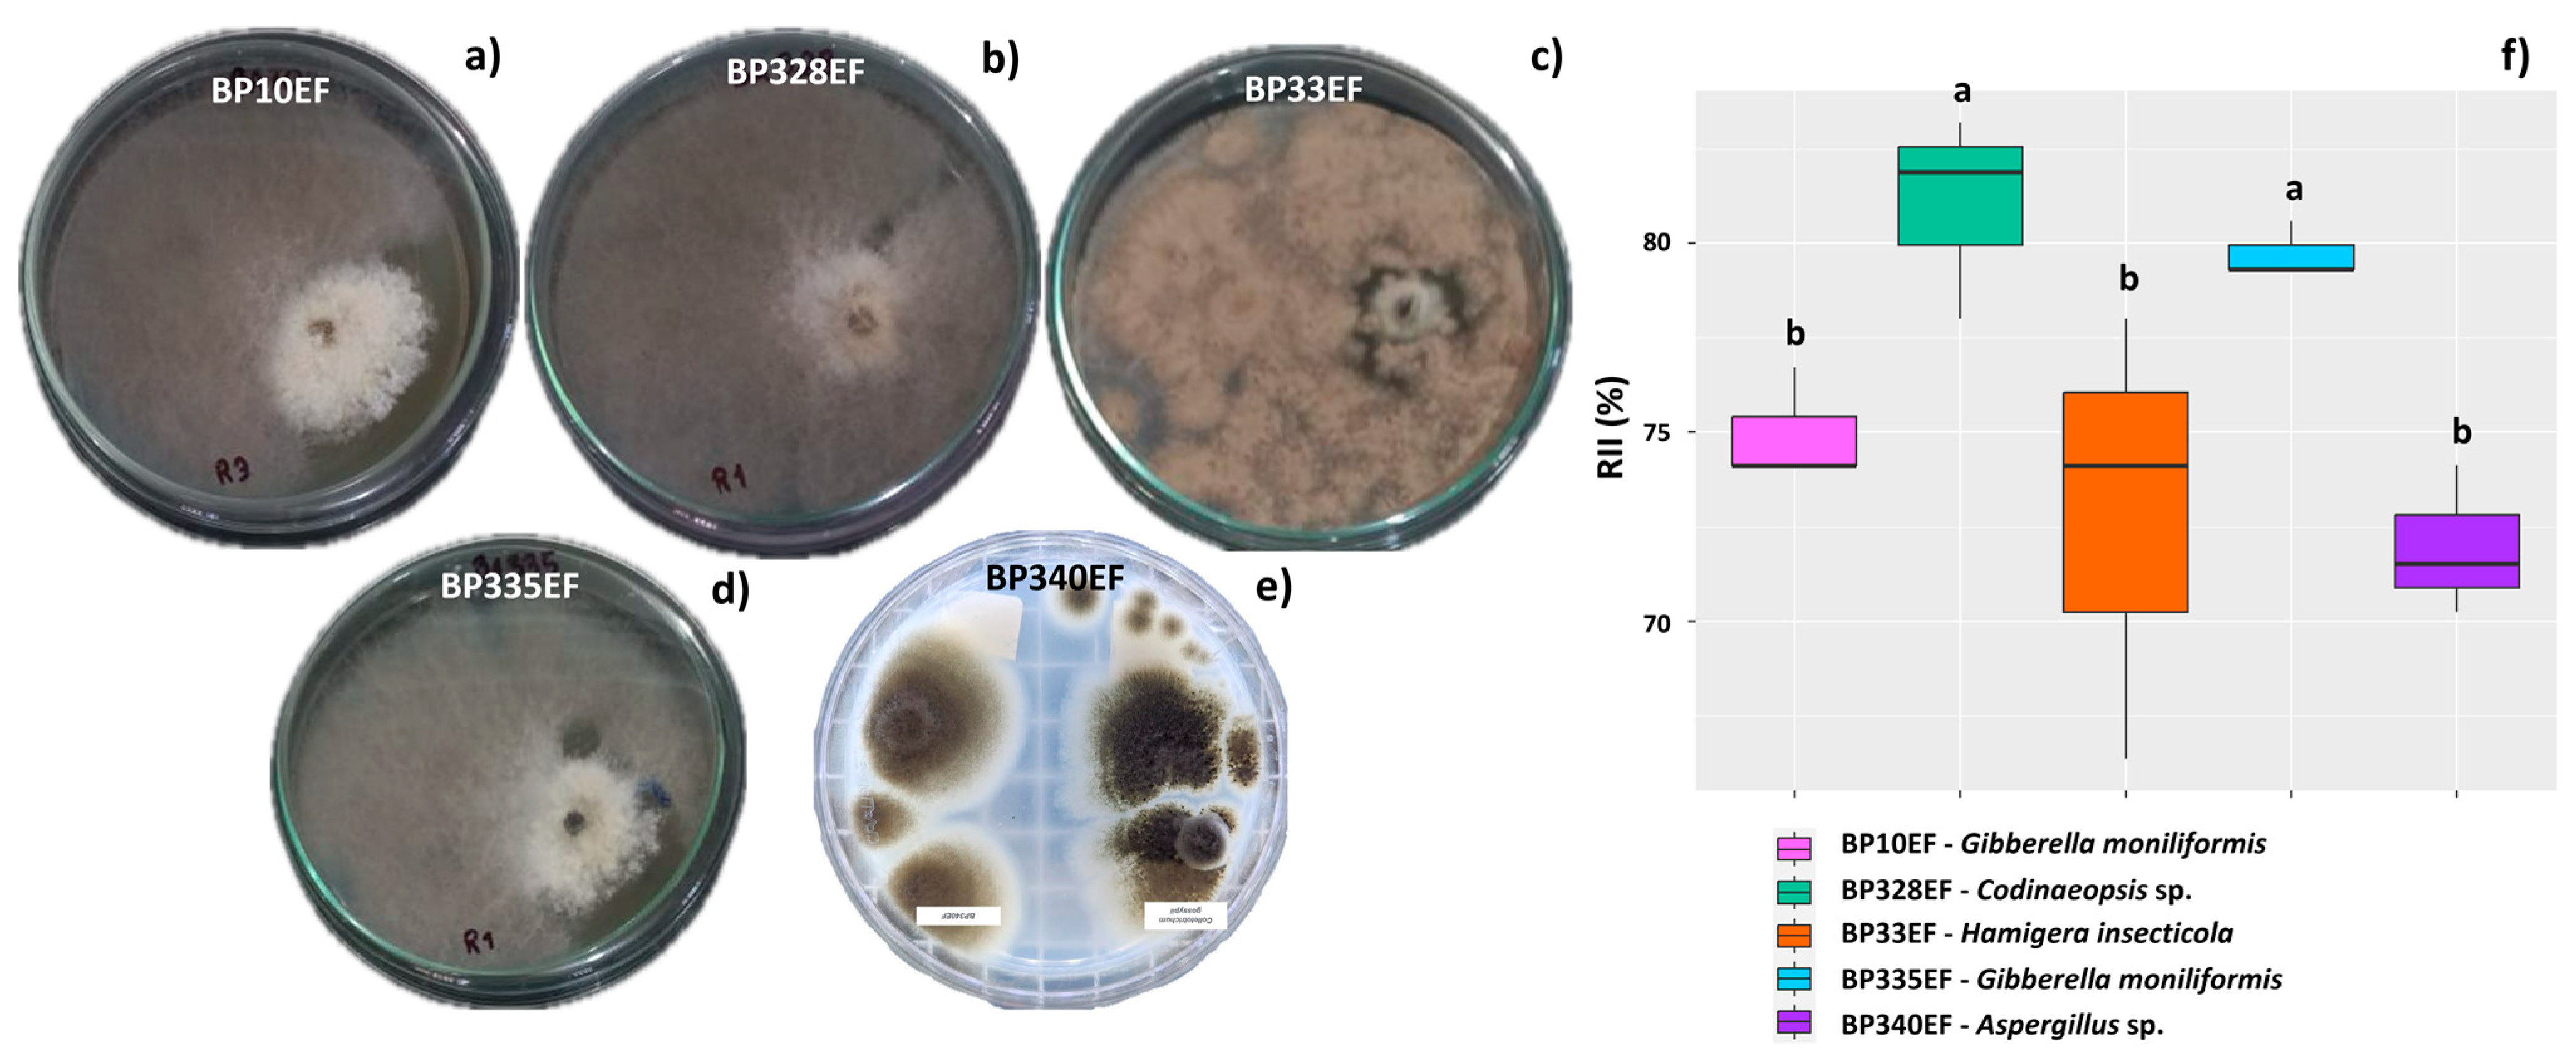
Microorganisms 12 01124 g002

Endophytic Fungi Inoculation Reduces Ramulosis Severity in Gossypium hirsutum Plants
Abstract
1. Introduction
2. Materials and Methods
2.1. Isolated Fungi and Seeds Contaminated with C. gossypii var. cephalosporioides
2.2. In Vitro Antibiosis Tests
2.3. Preparation of the Plant Substrate and Seed Planting
2.4. Biometric, Gas Exchange, and Chlorophyll-a Fluorescence Evaluations
2.5. Extraction and Activity of Antioxidant Metabolism Enzymes and Malondialdehyde (MDA)
2.6. Experimental Design and Statistical Analyses
3. Results
3.1. Antibiosis of Endophytic Strains of Colletotrichum gossypii var. cephalosporioides
3.2. Growth and Physiology of Cotton Plants Infected by Colletotrichum gossypii var. cephalosporioides and Subjected to Inoculation with Endophytic Strains
4. Discussion
4.1. Inoculation with Endophytic Fungi Mitigates Physiological and Photochemical Damage by Ramulosis in Cotton Plants
4.2. Endophytic Fungi Differentially Affect Growth, Gas Exchange, and Primary Photochemistry of Cotton Plants Affected by Ramulosis
4.3. The Codinaeopsis sp. Strain BP328EF Inhibits the In Vitro Growth of Colletotrichum gossypii var. cephalosporioides, Positively Affects Gas Exchange, and Reduces Chlorophyll-a Photochemical Stress and Lipid Peroxidation
5. Conclusions
Author Contributions
Funding
Data Availability Statement
Acknowledgments
Conflicts of Interest
References
- Tyagi, J.; Chaudhary, P.; Jyotsana, U.B.; Bhandari, G.; Chaudhary, A. Impact of endophytic fungi in biotic stress management. In Plant Protection: From Chemicals to Biologicals; Co, K.G., Ed.; Walter de Gruyter GmbH: Berlin, Germany, 2022; pp. 447–462. [Google Scholar] [CrossRef]
- Kamburova, V.; Salakhutdinov, I.; Abdurakhmonov, I.Y. Cotton breeding in the view of abiotic and biotic stresses: Challenges and perspectives. In Cotton; Abdurakhmonov, I.Y., Ed.; IntechOpen: London, UK, 2022. [Google Scholar] [CrossRef]
- Meyer, L.A.; Dew, T. Cotton and Wool Outlook: December 2021; US Department of Agriculture, Economic Research Service: Washington, DC, USA, 2021; p. 5542. Available online: https://www.ers.usda.gov/webdocs/outlooks/102828/cws-21k.pdf (accessed on 27 March 2023).
- Tarazi, R.; Jimenez, J.L.S.; Vaslin, M.F. Biotechnological solutions for major cotton (Gossypium hirsutum) pathogens and pests. Biotechnol. Res. Innov. 2019, 3, 19–26. [Google Scholar] [CrossRef]
- Cox, K.L.; Babilonia, T.W.; He, P.; Shan, L. Return of old foes—Recurrence of bacterial blight and Fusarium wilt of cotton. Curr. Opin. Plant Biol. 2019, 50, 95–103. [Google Scholar] [CrossRef] [PubMed]
- Zhu, Y.; Zhao, M.; Li, T.; Wang, L.; Liao, C.; Liu, D.; Li, B. Interactions between Verticillium dahliae and cotton: Pathogenic mechanism and cotton resistance mechanism to Verticillium wilt. Front. Plant Sci. 2023, 14, 1174281. [Google Scholar] [CrossRef] [PubMed]
- Shete, P.P.; Kasal, Y.G.; Perane, R.R. Screening of the cotton genotypes against Ramularia areola atk. under field condition. Plant Arch. 2018, 18, 734–736. [Google Scholar]
- Ghaffar, A. Biological control of sclerotial diseases. In Biocontrol of Plant Diseases; Mukerji, K.G., Garg, K.L., Eds.; CRC Press: Boca Raton, FL, USA, 2023; pp. 153–176. [Google Scholar]
- Makwana, N.; Rawal, P. Cultural, morphological and pathogenic variability of Colletotrichum gossypii causing anthracnose of cotton. J. Mycol. Plant Pathol. 2022, 52, 395–404. [Google Scholar]
- Salustiano, M.E.; Rondon, M.N.; Abreu, L.M.; Costa, S.S.; Costa, J.C.; Machado, L.H. The etiological agent of cotton ramulosis represents a single phylogenetic lineage within the Colletotrichum gloeosporioides species complex. Trop. Plant Pathol. 2014, 39, 357–367. [Google Scholar] [CrossRef]
- Moreno-Moran, M.; Burbano-Figueroa, O. Field resistance of advanced breeding lines of upland cotton to ramulosis caused by Colletotrichum gossypii var. cephalosporioides. Crop Prot. 2019, 122, 49–56. [Google Scholar] [CrossRef]
- Guerra, A.M.N.D.M.; Rodrigues, F.Á.; Lima, T.C.; Berger, P.G.; Barros, A.F.; Silva, Y.C.R.D. Photosynthetic capacity of cotton boll rot infected plants and supplied with silicon. Bragantia 2014, 73, 50–64. [Google Scholar] [CrossRef][Green Version]
- De Araújo, A.E.; Ferreira, A.D.B.; Morello, C.D.L. Damage caused in cotton by different levels of ramulosis in Brazil. In Proceedings of the World Cotton Research Conference-5, Mumbai, India, 7–11 November 2011; Volume 7, pp. 290–292. [Google Scholar]
- Joshua, J.; Mmbaga, M.T. Potential biological control agents for soilborne fungal pathogens in Tennessee snap bean farms. HortScience 2020, 755, 988–994. [Google Scholar] [CrossRef]
- Adeleke, B.S.; Ayilara, M.S.; Akinola, S.A.; Babalola, O.O. Biocontrol mechanisms of endophytic fungi. Egypt. J. Biol. Pest Control 2022, 32, 46. [Google Scholar] [CrossRef]
- Fontana, D.C.; De Paula, S.; Torres, A.G.; De Souza, V.H.M.; Pascholati, S.F.; Schmidt, D.; Dourado Neto, D. Endophytic fungi: Biological control and induced resistance to phytopathogens and abiotic stresses. Pathogens 2021, 10, 570. [Google Scholar] [CrossRef]
- Santra, H.K.; Banerjee, D. Fungal endophytes: A source for biological control agents. In Agriculturally Important Fungi for Sustainable Agriculture: Functional Annotation for Crop Protection; Yadav, A., Mishra, S., Kour, D., Yadav, N., Kumar, A., Eds.; Springer: Cham, Switzerland, 2020; Volume 2, pp. 181–216. [Google Scholar] [CrossRef]
- Hassani, M.A.; Duran, P.; Hacquard, S. Microbial interactions within the plant holobiont. Microbiome 2018, 6, 58. [Google Scholar] [CrossRef] [PubMed]
- Bard, N.W.; Cronk, Q.C.; Davies, T.J. Fungal endophytes can modulate plant invasion. Biol. Rev. 2024. [Google Scholar] [CrossRef] [PubMed]
- Jin, L.; Yang, L.; Li, W.; Xu, D.; Yang, N.; Li, G.; Wan, P. Diversity and biocontrol potential of culturable endophytic fungi in cotton. Front. Microbiol. 2021, 12, 698930. [Google Scholar] [CrossRef] [PubMed]
- Wei, F.; Zhang, Y.; Shi, Y.; Feng, H.; Zhao, L.; Feng, Z.; Zhu, H. Evaluation of the biocontrol potential of endophytic fungus Fusarium solani CEF559 against Verticillium dahliae in cotton plant. Biomed. Res. Int. 2019, 2019, 3187943. [Google Scholar] [CrossRef] [PubMed]
- Yuan, Y.; Feng, H.; Wang, L.; Li, Z.; Shi, Y.; Zhao, L.; Zhu, H. Potential of endophytic fungi isolated from cotton roots for biological control against verticillium wilt disease. PLoS ONE 2017, 12, e0170557. [Google Scholar] [CrossRef]
- Gasoni, L.; de Gurfinkel, S. Biocontrol of Rhizoctonia solani by the endophytic fungus Cladorrhinum foecundissimum in cotton plants. Australas. Plant Pathol. 2009, 38, 389–391. [Google Scholar] [CrossRef]
- Nawaz, H.H.; Rajaofera, M.N.; He, Q.; Anam, U.; Lin, C.; Miao, W. Evaluation of antifungal metabolites activity from Bacillus licheniformis OE-04 against Colletotrichum gossypii. Pestic. Biochem. Physiol. 2018, 146, 33–42. [Google Scholar] [CrossRef]
- Yadav, L.; Yadav, N.K.; Malik, V.K.; Yadav, P.; Yadav, N.; Vashisth, P.; Dhariwal, S. Evaluation of biological control agents against Colletotrichum gossypii under in vitro condition. Pharma Innov. J. 2012, 11, 3830–3832. [Google Scholar]
- Ferro, H.M.; Souza, R.; Lelis, F.; Vieira, M.; Silva, J.C.P.D.; Medeiros, F.H.V.D. Bacteria for cotton plant protection: Disease control, crop yield, and fiber quality. Rev. Caatinga 2020, 33, 43–53. [Google Scholar] [CrossRef]
- Araújo, D.V.; Zambenedetti, G.B.; Dallacort, R.; Azevedo, V.H.; Mainardi, J.T. Progresso da ramulose em campo a partir de sementes de algodoeiro inoculadas com Colletotrichum gossypii var. cephalosporioides. Trop. Plant Pathol. 2012, 37, 204–209. [Google Scholar] [CrossRef]
- Da Silva, C.F.; Vitorino, L.C.; Soares, M.A.; Souchie, E.L. Multifunctional potential of endophytic and rhizospheric microbial isolates associated with Butia purpurascens roots. Antonie Van Leeuwenhoek 2018, 111, 2157–2174. [Google Scholar] [CrossRef] [PubMed]
- Dos Reis, J.B.A.; do Vale, H.M.M.; Lorenzi, A.S. Insights into taxonomic diversity and bioprospecting potential of Cerrado endophytic fungi: A review exploring a unique Brazilian biome and methodological limitations. World J. Microbiol. Biotechnol. 2022, 38, 202. [Google Scholar] [CrossRef] [PubMed]
- Noriler, S.A.; Savi, D.C.; Aluizio, R.; Palacio-Cortes, A.M.; Possiede, Y.M.; Glienke, C. Bioprospecting and structure of fungal endophyte communities found in the Brazilian biomes, Pantanal, and Cerrado. Front. Microbiol. 2018, 9, 1526. [Google Scholar] [CrossRef] [PubMed]
- Talhinhas, P.; Baroncelli, R. Colletotrichum species and complexes: Geographic distribution, host range and conservation status. Fungal Divers. 2021, 110, 109–198. [Google Scholar] [CrossRef]
- Chhabra, R.; Kaur, S.; Vij, L.; Gaur, K. Exploring physiological and biochemical factors governing plant pathogen interaction: A review. Int. J. Curr. Microbiol. App. Sci. 2020, 9, 1650–1666. [Google Scholar] [CrossRef]
- Xing, J.; Li, M.; Li, J.; Shen, W.; Li, P.; Zhao, J.; Zhang, Y. Stem canker pathogen Botryosphaeria dothidea inhibits poplar leaf photosynthesis in the early stage of inoculation. Front. Plant Sci. 2022, 13, 1008834. [Google Scholar] [CrossRef] [PubMed]
- Yang, H.; Luo, P. Changes in photosynthesis could provide important insight into the interaction between wheat and fungal pathogens. Int. J. Mol. Sci. 2021, 22, 8865. [Google Scholar] [CrossRef] [PubMed]
- Yahya, M.; Saeed, N.A.; Nadeem, S.; Hamed, M.; Saleem, K. Effect of leaf rust disease on photosynthetic rate, chlorophyll contents, and grain yield of wheat. Arch. Phytopathol. Plant Prot. 2020, 53, 425–439. [Google Scholar] [CrossRef]
- Lu, Y.; Yao, J. Chloroplasts at the crossroad of photosynthesis, pathogen infection and plant defense. Int. J. Mol. Sci. 2018, 19, 3900. [Google Scholar] [CrossRef] [PubMed]
- Gahir, S.; Bharath, P.; Raghavendra, A.S. Stomatal closure sets in motion long-term strategies of plant defense against microbial pathogens. Front. Plant Sci. 2021, 12, 761952. [Google Scholar] [CrossRef] [PubMed]
- Grimmer, M.K.; John Foulkes, M.; Paveley, N.D. Foliar pathogenesis and plant water relations: A review. J. Exp. Bot. 2012, 63, 4321–4331. [Google Scholar] [CrossRef] [PubMed]
- Goyal, A.; Parashar, M. Organic cotton and BCI-certified cotton fibres. In Sustainable Fibres for Fashion and Textile Manufacturing; Nayak, R., Ed.; Woodhead Publishing: Sawston, UK, 2023; pp. 51–74. [Google Scholar]
- Cabanillas, C.; Tablada, M.; Ferreyra, L.; Pérez, A.; Sucani, G. Sustainable management strategies focused on native bio-inputs in Amaranthus cruentus L. in agroecological farms in transition. J. Clean. Prod. 2017, 142, 343–350. [Google Scholar] [CrossRef]
- Reis, M.N.O.; Vitorino, L.C.; Lourenço, L.L.; Bessa, L.A. Microbial inoculation improves growth, nutritional and physiological aspects of Glycine max (L.) Merr. Microorganisms 2022, 10, 1386. [Google Scholar] [CrossRef] [PubMed]
- Strasser, R.J.; Srivastava, A.; Tsimilli-Michael, M. The fluorescence transient as a tool to characterize and screen photosynthetic samples. In Probing Photosynthesis: Mechanisms, Regulation and Adaptation; CRC Press: Boca Raton, FL, USA, 2000; pp. 445–483. [Google Scholar]
- Biemelt, S.; Keetman, U.; Albrecht, G. Re-aeration following hypoxia or anoxia leads to activation of the antioxidative defense system in roots of wheat seedlings. Plant Physiol. 1998, 116, 651–658. [Google Scholar] [CrossRef] [PubMed]
- Havir, E.A.; McHale, N.A. Biochemical and developmental characterization of multiple forms of catalase in tobacco leaves. Plant Physiol. 1987, 84, 450–455. [Google Scholar] [CrossRef] [PubMed]
- Nakano, Y.; Asada, K. Hydrogen peroxide is scavenged by ascorbate-specific peroxidase in spinach chloroplasts. Plant Cell Physiol. 1981, 22, 867–880. [Google Scholar] [CrossRef]
- Fang, W.-C.; Kao, C.H. Enhanced peroxidase activity in rice leaves in response to excess iron, copper and zinc. Plant Sci. 2000, 158, 71–76. [Google Scholar] [CrossRef] [PubMed]
- Bradford, M.M. A rapid and sensitive method for the quantitation of microgram quantities of protein utilizing the principle of protein-dye binding. Anal. Biochem. 1976, 72, 248–254. [Google Scholar] [CrossRef] [PubMed]
- Giannopolitis, C.N.; Ries, S.K. Superoxide dismutases: I. Occurrence in higher plants. Plant Physiol. 1977, 59, 309–314. [Google Scholar] [CrossRef] [PubMed]
- Buege, J.A.; Aust, S.D. Microsomal lipid peroxidation. In Methods in Enzymology; Qin, P.Z., Ed.; Academic Press: New York, NY, USA, 1978; pp. 302–310. [Google Scholar] [CrossRef]
- R Core Team. R: A Language and Environment for Statistical Computing [Software]; R Foundation for Statistical Computing: Vienna, Austria, 2024; Available online: https://www.R-project.org/ (accessed on 27 March 2023).
- Sokal, R.R.; Rohlf, F.J. The comparison of dendrograms by objective methods. Taxon 1962, 11, 33–40. [Google Scholar] [CrossRef]
- Garcia-Vallve, S.; Palau, J.; Romeu, A. Horizontal gene transfer in glycosyl hydrolases inferred from codon usage in Escherichia coli and Bacillus subtilis. Mol. Biol. Evol. 1999, 16, 1125–1134. [Google Scholar] [CrossRef] [PubMed]
- Haas, D.; Keel, C. Regulation of antibiotic production in root-colonizing Pseudomonas spp. and relevance for biological control of plant disease. Annu. Rev. Phytopathol. 2003, 41, 117–153. [Google Scholar] [CrossRef] [PubMed]
- Lu, H.; Wei, T.; Lou, H.; Shu, X.; Chen, Q. A critical review on communication mechanism within plant-endophytic fungi interactions to cope with biotic and abiotic stresses. J. Fungi 2021, 7, 719. [Google Scholar] [CrossRef] [PubMed]
- Yan, L.; Zhu, J.; Zhao, X.; Shi, J.; Jiang, C.; Shao, D. Beneficial effects of endophytic fungi colonization on plants. Appl. Microbiol. Biotechnol. 2019, 103, 3327–3340. [Google Scholar] [CrossRef] [PubMed]
- Latz, M.A.; Jensen, B.; Collinge, D.B.; Jørgensen, H.J. Endophytic fungi as biocontrol agents: Elucidating mechanisms in disease suppression. Plant Ecol. Divers. 2018, 11, 555–567. [Google Scholar] [CrossRef]
- Poveda, J. Trichoderma as biocontrol agent against pests: New uses for a mycoparasite. Biol. Control 2021, 159, 104634. [Google Scholar] [CrossRef]
- Eo, J.K.; Choi, M.S.; Eom, A.H. Diversity of endophytic fungi isolated from Korean ginseng leaves. Mycobiology 2014, 42, 147–151. [Google Scholar] [CrossRef] [PubMed]
- Desjardins, A.E.; Busman, M.; Muhitch, M.; Proctor, R.H. Complementary host–pathogen genetic analyses of the role of fumonisins in the Zea mays–Gibberella moniliformis interaction. Physiol. Mol. Plant Pathol. 2007, 70, 149–160. [Google Scholar] [CrossRef] [PubMed]
- Kim, J.W.; Ryu, J.; Shim, S.H. Chemical investigation on an endophytic fungus Gibberella moniliformis JS1055 derived from a halophyte Vitex rotundifolia. Nat. Prod. Sci. 2018, 24, 189–193. [Google Scholar] [CrossRef]
- Sarang, H.; Rajani, P.; Vasanthakumari, M.M.; Kumara, P.M.; Siva, R.; Ravikanth, G.; Uma Shaanker, R. An endophytic fungus, Gibberella moniliformis from Lawsonia inermis L. produces lawsone, an orange-red pigment. Antonie Van Leeuwenhoek 2017, 110, 853–862. [Google Scholar] [CrossRef] [PubMed]
- Proctor, R.H.; Brown, D.W.; Plattner, R.D.; Desjardins, A.E. Co-expression of 15 contiguous genes delineates a fumonisin biosynthetic gene cluster in Gibberella moniliformis. Fungal Genet. Biol. 2003, 38, 237–249. [Google Scholar] [CrossRef] [PubMed]
- Ibrahim, S.R.; Elkhayat, E.S.; Mohamed, G.A.; Khedr, A.I.; Fouad, M.A.; Kotb, M.H.; Ross, S.A. Aspernolides F and G, new butyrolactones from the endophytic fungus Aspergillus terreus. Phytochem. Lett. 2015, 14, 84–90. [Google Scholar] [CrossRef] [PubMed]
- Bai, Z.-Q.; Lin, X.; Wang, J.; Wang, Y.; Zhou, X.; Yang, B.; Liu, J.; Wang, Y.; Liu, Y. New phenyl derivatives from endophytic fungus Aspergillus flavipes AIL8 derived of mangrove plant Acanthus ilicifolius. Fitoterapia 2014, 95, 194–202. [Google Scholar] [CrossRef] [PubMed]
- El-Hawary, S.S.; Moawad, A.S.; Bahr, H.S.; Abdelmohsen, U.R.; Mohammed, R. Natural product diversity from the endophytic fungi of the genus Aspergillus. RSC Adv. 2020, 10, 22058–22079. [Google Scholar] [CrossRef] [PubMed]
- Verma, V.C.; Kharwar, R.N.; Gange, A.C. Biosynthesis of antimicrobial silver nanoparticles by the endophytic fungus Aspergillus clavatus. Nanomedicine 2010, 5, 33–40. [Google Scholar] [CrossRef] [PubMed]
- Ramanathan, M.; Tan, C.J.; Chang, W.J.; Tsai, H.H.G.; Hou, D.R. Synthesis of the decalin core of codinaeopsin via an intramolecular Diels–Alder reaction. Org. Biomol. Chem. 2013, 11, 3846–3854. [Google Scholar] [CrossRef] [PubMed]
- Kontinik, R.; Clardy, J. Codinaeopsin, an antimalarial fungal polyketide. Org. Lett. 2008, 10, 4149–4151. [Google Scholar] [CrossRef] [PubMed]
- Breinholt, J.; Kjoer, A.; Olsen, C.E.; Rassing, B.R. Hamigerone and dihydrohamigerone: Tvvo acetate-derived, antifungal metabolites from Hamigera. Acta Chem. Scand. 1997, 51, 1241–1244. [Google Scholar] [CrossRef]
- Mistry, H.; Thakor, R.; Polara, H.; Shah, T.; Bariya, H. Biogenically efficient production and characterization of silver nanoparticles using the marine fungus Hamigera terricola along with their antimicrobial and antioxidative efficacy. In Nanotechnology and In Silico Tools; Kaneria, M., Rakholiya, K., Egbuna, C., Eds.; Elsevier: Amsterdam, The Netherlands, 2024; pp. 89–96. [Google Scholar] [CrossRef]
- Baron, N.C.; Rigobelo, E.C. Endophytic fungi: A tool for plant growth promotion and sustainable agriculture. Mycology 2022, 13, 39–55. [Google Scholar] [CrossRef] [PubMed]
- Poveda, J.; Eugui, D.; Abril-Urías, P.; Velasco, P. Endophytic fungi as direct plant growth promoters for sustainable agricultural production. Symbiosis 2021, 85, 1–19. [Google Scholar] [CrossRef]
- Russo, M.L.; Pelizza, S.A.; Vianna, M.F.; Allegrucci, N.; Cabello, M.N.; Toledo, A.V.; Scorsetti, A.C. Effect of endophytic entomopathogenic fungi on soybean Glycine max (L.) Merr. growth and yield. J. King Saud Univ.-Sci. 2019, 31, 728–736. [Google Scholar] [CrossRef]
- Galeano, R.M.S.; Franco, D.G.; Chaves, P.O.; Giannesi, G.C.; Masui, D.C.; Ruller, R.; Zanoelo, F.F. Plant growth-promoting potential of endophytic Aspergillus niger 9-p isolated from native forage grass in Pantanal of Nhecolândia region, Brazil. Rhizosphere 2021, 18, 100332. [Google Scholar] [CrossRef]
- Hamayun, M.; Hussain, A.; Khan, S.A.; Iqbal, A.; Lee, I.J. Aspergillus flavus promoted the growth of soybean and sunflower seedlings at elevated temperature. BioMed Res. Int. 2019, 2019, 1295457. [Google Scholar] [CrossRef] [PubMed]
- Ismail; Hamayun, M.; Hussain, A.; Iqbal, A.; Khan, S.A.; Lee, I.J. Aspergillus niger boosted heat stress tolerance in sunflower and soybean via regulating their metabolic and antioxidant system. J. Plant Interact. 2020, 15, 223–232. [Google Scholar] [CrossRef]
- Asaf, S.; Hamayun, M.; Khan, A.L.; Waqas, M.; Khan, M.A.; Jan, R.; Hussain, A. Salt tolerance of Glycine max L. induced by endophytic fungus Aspergillus flavus CSH1, via regulating its endogenous hormones and antioxidative system. Plant Physiol. Biochem. 2018, 128, 13–23. [Google Scholar] [CrossRef] [PubMed]
- Khan, A.L.; Hamayun, M.; Kim, Y.H.; Kang, S.M.; Lee, J.H.; Lee, I.J. Gibberellins producing endophytic Aspergillus fumigatus sp. LH02 influenced endogenous phytohormonal levels, isoflavonoids production and plant growth in salinity stress. Process Biochem. 2011, 46, 440–447. [Google Scholar] [CrossRef]
- Saxena, J.; Rawat, J.; Sanwal, P. Enhancement of growth and yield of Glycine max plants with inoculation of phosphate solubilizing fungus Aspergillus niger K7 and biochar amendment in soil. Commun. Soil Sci. Plant Anal. 2016, 47, 2334–2347. [Google Scholar] [CrossRef]
- Nayak, S.; Samanta, S.; Mukherjee, A.K. Beneficial role of Aspergillus sp. in agricultural soil and environment. In Frontiers in Soil and Environmental Microbiology; CRC Press: Boca Raton, FL, USA, 2020; Volume 1, pp. 17–36. ISBN 9780429485794. [Google Scholar]
- Radhakrishnan, R.; Khan, A.L.; Kang, S.M.; Lee, I.J. A comparative study of phosphate solubilization and the host plant growth promotion ability of Fusarium verticillioides RK01 and Humicola sp. KNU01 under salt stress. Ann. Microbiol. 2015, 65, 585–593. [Google Scholar] [CrossRef]
- Melotto, M.; Zhang, L.; Oblessuc, P.R.; He, S.Y. Stomatal defense a decade later. Plant Physiol. 2017, 174, 561–571. [Google Scholar] [CrossRef] [PubMed]
- Murray, R.R.; Emblow, M.S.; Hetherington, A.M.; Foster, G.D. Plant virus infections control stomatal development. Sci. Rep. 2016, 6, 34507. [Google Scholar] [CrossRef] [PubMed]
- Muir, C.D. A stomatal model of anatomical tradeoffs between gas exchange and pathogen colonization. Front. Plant Sci. 2020, 11, 518991. [Google Scholar] [CrossRef] [PubMed]
- Maire, R. Fungi Catalaunici: Series Altera. Contributions à L’étude de la Flore Mycologique de la Catalogne; Institut Botànic de Barcelona: Barcelona, Spain, 1937; Volume 3, pp. 1–128. [Google Scholar]
- Réblová, M.; Kolařík, M.; Nekvindová, J.; Réblová, K.; Sklenář, F.; Miller, A.N.; Hernández-Restrepo, M. Phylogenetic reassessment, taxonomy, and biogeography of Codinaea and similar fungi. J. Fungi 2021, 7, 1097. [Google Scholar] [CrossRef] [PubMed]
- Salhi, L.N.; Bustamante Villalobos, P.; Forget, L.; Burger, G.; Lang, B.F. Endosymbionts in cranberry: Diversity, effect on plant growth, and pathogen biocontrol. Plants People Planet 2022, 4, 511–522. [Google Scholar] [CrossRef]

Disclaimer/Publisher’s Note: The statements, opinions and data contained in all publications are solely those of the individual author(s) and contributor(s) and not of MDPI and/or the editor(s). MDPI and/or the editor(s) disclaim responsibility for any injury to people or property resulting from any ideas, methods, instructions or products referred to in the content. |
© 2024 by the authors. Licensee MDPI, Basel, Switzerland. This article is an open access article distributed under the terms and conditions of the Creative Commons Attribution (CC BY) license (https://creativecommons.org/licenses/by/4.0/).
Share and Cite
Silva, I.d.O.; Bessa, L.A.; Reis, M.N.O.; Augusto, D.S.S.; Roweder, C.; Souchie, E.L.; Vitorino, L.C. Endophytic Fungi Inoculation Reduces Ramulosis Severity in Gossypium hirsutum Plants. Microorganisms 2024, 12, 1124. https://doi.org/10.3390/microorganisms12061124
Silva IdO, Bessa LA, Reis MNO, Augusto DSS, Roweder C, Souchie EL, Vitorino LC. Endophytic Fungi Inoculation Reduces Ramulosis Severity in Gossypium hirsutum Plants. Microorganisms. 2024; 12(6):1124. https://doi.org/10.3390/microorganisms12061124
Chicago/Turabian StyleSilva, Isabella de Oliveira, Layara Alexandre Bessa, Mateus Neri Oliveira Reis, Damiana Souza Santos Augusto, Charlys Roweder, Edson Luiz Souchie, and Luciana Cristina Vitorino. 2024. "Endophytic Fungi Inoculation Reduces Ramulosis Severity in Gossypium hirsutum Plants" Microorganisms 12, no. 6: 1124. https://doi.org/10.3390/microorganisms12061124
APA StyleSilva, I. d. O., Bessa, L. A., Reis, M. N. O., Augusto, D. S. S., Roweder, C., Souchie, E. L., & Vitorino, L. C. (2024). Endophytic Fungi Inoculation Reduces Ramulosis Severity in Gossypium hirsutum Plants. Microorganisms, 12(6), 1124. https://doi.org/10.3390/microorganisms12061124

